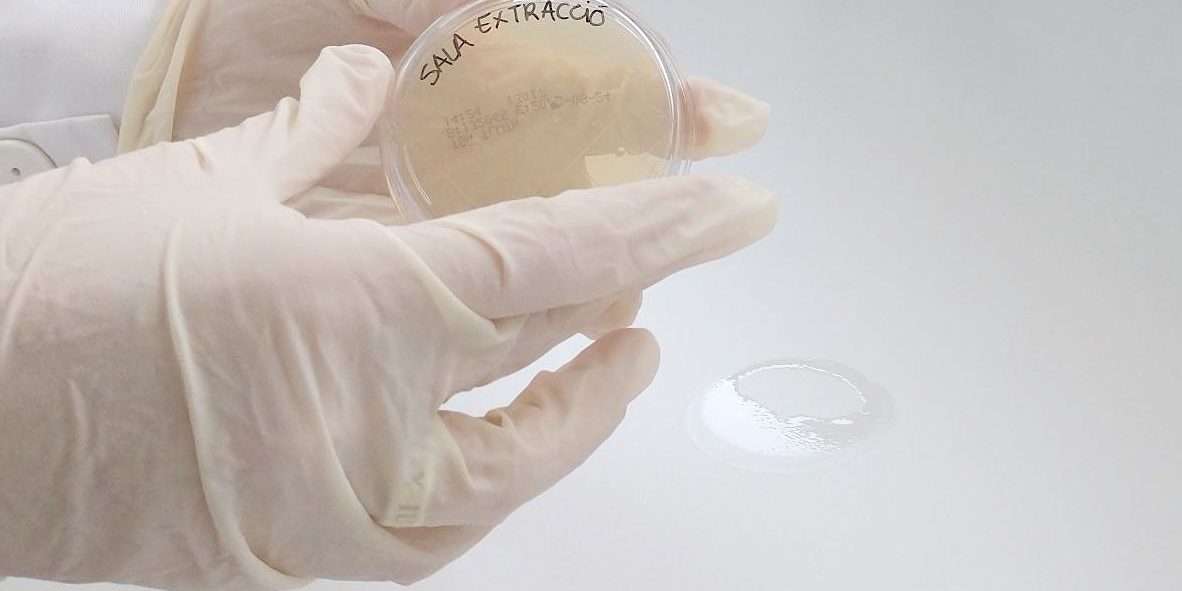
1650614107893

Conocer y controlar la población microbiana presente en las superficies y ambientes de las diferentes zonas de un laboratorio, es fundamental para asegurar un espacio seguro, para las personas trabajadoras y para las muestras que se procesan.
Gracias a esta información evitamos contaminaciones cruzadas.
Para asegurar una zona limpia y libre de posibles patógenos es necesario realizar un plan de limpieza periódico, así como incluir análisis ambientales y de superficies, que nos permitan generar una estimación total del número de bacterias presentes.
En Zenit realizamos estos controles de forma quincenal en nuestras zonas de trabajo, para garantizar la mejor eficacia y protección para el cliente y para nuestro equipo de profesionales.